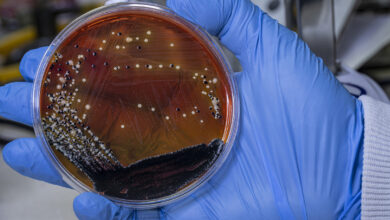

إطلاق حزمة مزايا جديدة في “يوتيوب”


من أبرز الإضافات التي أثارت الانتباه، تمكين المشتركين من تسريع تشغيل مقاطع الفيديو حتى 4 مرات، مع إتاحة زيادات دقيقة تصل إلى 0.05x.
هذه الميزة أصبحت متوفرة عبر تطبيق يوتيوب على أنظمة أندرويد وiOS إلى جانب النسخة المخصصة للويب.
ولم تقتصر التحديثات على جانب الفيديو فقط، إذ أصبح بوسع مشتركي “Premium” الاستماع إلى المقاطع بجودة صوت محسّنة تبلغ 256 كيلوبت في الثانية على التطبيق الأساسي ليوتيوب.
الميزة تدعم المقاطع الموسيقية الرسمية و”Art Tracks”، تمامًا كما هو الحال في تطبيق “موسيقى يوتيوب”.
واستهدفت المنصة أيضًا مستخدمي أجهزة التلفزيون الذكية ووحدات الألعاب عبر خاصية جديدة تحمل اسم “Jump Ahead”، حيث تتيح لهم الانتقال مباشرة إلى أكثر اللحظات إثارة أو إلى اللقطات المهمة التي قد تكون فاتتهم أثناء المشاهدة.
التحديثات الأخيرة جلبت كذلك ميزة “Picture-in-Picture” لمقاطع الفيديو القصيرة “Shorts”، ما يسمح باستمرار تشغيلها في نافذة صغيرة أثناء تصفح محتوى آخر على الجهاز.
كما أُضيفت خاصية التنزيلات الذكية، التي تقوم تلقائيًا بحفظ مقاطع “Shorts” المفضلة للمستخدم بالاعتماد على سجل المشاهدة.
وبحسب ما أورده موقع NewsBytes المتخصص في أخبار التكنولوجيا، فإن يوتيوب لم تعد تشترط الدخول إلى موقعها الإلكتروني من أجل تفعيل هذه المزايا، بل باتت متاحة بشكل مباشر عبر التطبيق والنسخة المخصصة للويب، الأمر الذي يجعل تجربة الاستخدام أكثر سلاسة وانسيابية.
تنويه من موقع “بتوقيت بيروت”:
تم جلب هذا المحتوى بشكل آلي من المصدر:
arabicradio.net
بتاريخ: 2025-09-29 00:37:00.
الآراء والمعلومات الواردة في هذا المقال لا تعبر بالضرورة عن رأي موقع “بتوقيت بيروت”، والمسؤولية الكاملة تقع على عاتق المصدر الأصلي.
ملاحظة: قد يتم استخدام الترجمة الآلية في بعض الأحيان لتوفير هذا المحتوى.
ظهرت المقالة إطلاق حزمة مزايا جديدة في “يوتيوب” أولاً على بتوقيت بيروت.